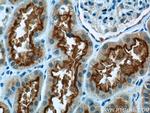
RIMBP2 Antibody in Immunohistochemistry (Paraffin) (IHC (P))

Search
Proteintech
RIMBP2 Polyclonal Antibody
{{$productOrderCtrl.translations['antibody.pdp.commerceCard.promotion.promotions']}}
{{$productOrderCtrl.translations['antibody.pdp.commerceCard.promotion.viewpromo']}}
{{$productOrderCtrl.translations['antibody.pdp.commerceCard.promotion.promocode']}}: {{promo.promoCode}} {{promo.promoTitle}} {{promo.promoDescription}}. {{$productOrderCtrl.translations['antibody.pdp.commerceCard.promotion.learnmore']}}
产品信息
15716-1-AP
种属反应
已发表种属
宿主/亚型
分类
类型
抗原
偶联物
形式
浓度
规格
纯化类型
保存液
内含物
保存条件
运输条件
产品详细信息
Immunogen sequence: MNGLATSLG KGQESAIGGS SAIGEYIRPL PQPGDRPEPL SAKPTFLSRS GSARCRSESD MENERNSNTS KQRYSGKVHL CVARYSYNPF DGPNENPEAE LPLTAGKYLY VYGDMDEDGF YEGELLDGQR GLVPSNFVDF VQDNESRLAS TLGNEQDQNF INHSGIGLEG EHILDLHSPT HIDAGITDNS AGTLDVNIDD IGEDIVPYPR KITLIKQLAK SVIVGWEPPA VPPGWGTVSS YNVLVDKETR MNLTLGSRTK ALIEKLNMAA CTYRISVQCV TSRGSSDELQ CTLLVGKDVV VAPSHLRVDN ITQISAQLSW LPTNSNYSHV IFLNEEEFDI VKAARYKYQF F (1-350 aa encoded by BC007632)
靶标信息
The presynaptic active zone mediates synaptic vesicle exocytosis at a synapse. RIM proteins are active zone scaffolding molecules that--among others--mediate vesicle priming and directly or indirectly interact with most other essential presynaptic proteins. RIMBP2 encodes RIMS-binding protein 2 belonging to RIMBP family. RIMBP2 is supposed to be localized at cell membrane especially synaptic plasma membrane. By interacting with RIMS1, RIMS2, CACNA1D and CACNA1B via the SH3 domains, RIMBP2 mediates synaptic transmission as bifunctional linker.
仅用于科研。不用于诊断过程。未经明确授权不得转售。
生物信息学
蛋白别名: KIAA0318; protein phosphatase 1, regulatory subunit 133; RIM binding protein 2; RIM-BP2; RIMS-binding protein 2
基因别名: A930033C01Rik; KIAA0318; mKIAA0318; PPP1R133; RBP2; RIM-BP2; RIMBP2
UniProt ID: (Human) O15034, (Mouse) Q80U40
Entrez Gene ID: (Human) 23504, (Rat) 266780, (Mouse) 231760